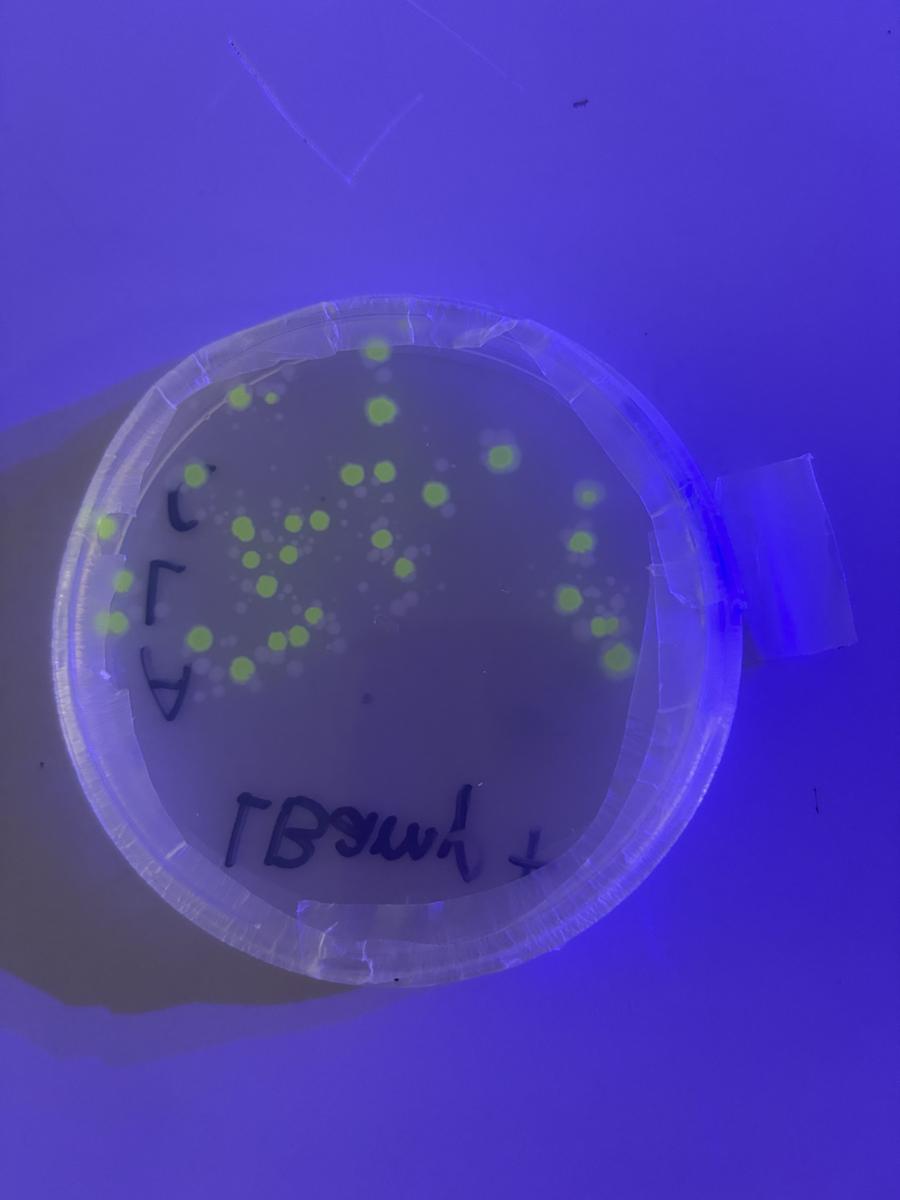
Gallery Image
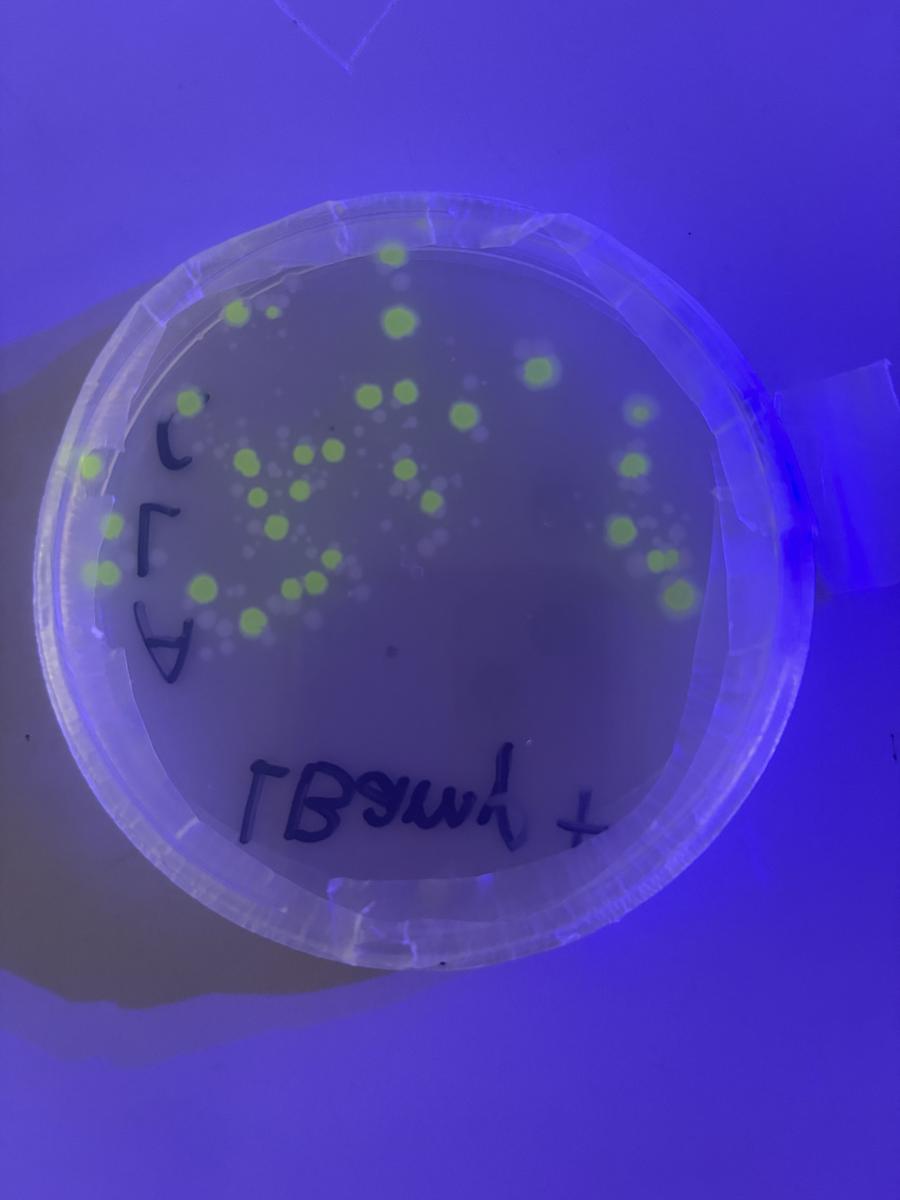
Gallery Image

Our Latest Facebook & Instagram Posts

For those not on social media OR those who do follow us but may have missed a post here or there! Here's what's been posted on our Facebook & Instagram pages since our last newsletter. Of course, if you would like to follow us to get the news as soon as it happens, here are the links!Â
Please note that Insta/FB 'stories' are not included on this page - these are only available on our Facebook and Instagram.Â
FRIDAY 20 MARCH 2026Â
YOUTH LEADERSHIP ACADEMY AUSTRALIA || Yesterday a group of our students attended the Youth Leadership Academy Australia Conference, exploring key themes including self-leadership, communication and creating positive change. Students heard from an exciting line-up of guest speakers including the founder of the HerHelp App Lexi McDonald, Lucy Thomas from Project Rockit and Will Massara, founder of Youth Leadership Academy Australia.
FRIDAY 20 MARCH 2026Â
INTERMEDIATE VOLLEYBALL BOYS & GIRLS || Yesterday our Year 9 & 10 students hit the courts for Intermediate Volleyball, with both our Boys and Girls A & B teams representing the College with pride. All teams played exceptionally well, showing great teamwork, determination and sportsmanship throughout the day. Placings are still to be confirmed, but we couldn’t be prouder of the way our students supported each other and gave it their all!Â
FRIDAY 20 MARCH 2026Â
UNIT 1 ECONOMICS – QUEEN VICTORIA MARKET || Today our Unit 1 Economics students visited Queen Victoria Market, using the iconic Melbourne market as a real-world case study to explore how markets operate. Working in groups, students gathered evidence to analyse competition and market power, which will inform the economic reports they are preparing as part of their assessment.
SATURDAY 21 MARCH 2026Â
MODEL UN || Yesterday a group of our students represented Beaumaris Secondary College at a Model United Nations event at Brighton Grammar. Taking on the role of UN member states, students debated the topic Artificial Intelligence and Sustainable Development: Harnessing the Benefits – Safeguarding Human Rights, while developing their negotiation, public speaking and collaboration skills.
SATURDAY 21 MARCH 2026Â
LUNCHTIME CONCERT VIBES|| With guitars plugged in and voices filling the amphitheatre, it was the ultimate way to spend a sunny Friday lunchbreak. A huge congratulations to all the students who performed, sharing your talent and passion made it a fantastic experience for everyone. We love seeing our school community come together through music!Â
MONDAY 23 MARCH 2026
STUDENT-LED HOUSE ATHLETICS RALLY || Today we held our first ever fully student-led assembly, with our Year Level, Sport and House Captains taking the lead in preparing the college for House Athletics.
Â
From introducing the Bigger Buddy System to creative and engaging segments that brought plenty of energy and House spirit, our student leaders did an outstanding job setting the tone for the upcoming carnival.
Â
And yes — even Mr Katz stepped up for a karaoke demonstration!
MONDAY 23 MARCH 2026Â
SENIOR FUTSAL, VOLLEYBALL & BASKETBALL || Our Senior teams took to the courts today for a round robin competition against other schools in our division. Across futsal, volleyball and basketball, our students represented the college with energy, teamwork and determination, showcasing their skills and supporting one another throughout the day.
Â
A standout performance from our Senior Girls Basketball team saw them finish as runners-up after a strong day of competition. Boys Futsal progressed through to the finals, while our Senior Girls Futsal secured 3rd place after a nail-biting double round of penalty shootouts in their semi-final. Senior Boys Volleyball and Senior Boys Basketball also progressed to the semi-finals, competing strongly across the day.
MONDAY 23 MARCH 2026
SENIOR GIRLS FUTSAL IN ACTION || Through the lens of our players! A great snapshot of the day — from warm-up to goals — as the team secured 3rd place after a thrilling semi-final.
TUESDAY 24 MARCH 2026
YEAR 7 MATHS IN ACTION || From lolly snake stretches to Smarties comparisons, our Year 7 students have been busy exploring data in hands-on and collaborative ways over the past few weeks.
Â
Across a range of activities, including data collection challenges and problem-based learning tasks, students have been applying their understanding of frequency tables, graphs and key statistics such as mean, median, mode and range to real-world contexts.
TUESDAY 24 MARCH 2026
REGIONAL SWIMMING SUCCESS || Our swimmers delivered outstanding performances at the Regional Swimming Championships yesterday, finishing 8th overall out of 51 schools — a fantastic result! Congratulations to the following students who placed first in their events and have now qualified for the State Championships next term:
Â
- Louis Sherratt – Men 16–20, 200m Freestyle and 100m Butterfly
- Eve Anderson – Women 18–20, 100m Butterfly, 50m Butterfly and 50m Freestyle
- Pippa Mulvany – Women 12–13, 50m Freestyle
- Will Panozzo – Men 18–20, 50m Butterfly
- Eve Anderson, Katie Gorvett-Page, Gemma Hogarty and Sophia Harpley – Women 18–20, 200m Freestyle Relay
- Will Panozzo, Keegan Bylsma, Oliver Harvey-Fuelling and Louis Sherratt – Men 18–20, 200m Freestyle Relay
WEDNESDAY 25 MARCH 2026
YEAR 7 CREATE PERFORMANCE || Our Year 7 Create Performance students took to the stage to present their Scripted Performance PBL, working in pairs or small groups to develop and perform their own interpretations of a script. Applying the Elements of Drama, students collaborated to rehearse and refine their performances, using expressive skills to bring their characters to life.
Â
It was fantastic to see the creativity, teamwork and confidence on display as students performed for their peers.
WEDNESDAY 25 MARCH 2026
YEAR 7 FOOD STUDIES PBL || Our Year 7 Innovate students took part in an exciting Term 1 Food Studies PBL, where they designed and created their own rolled food item. Working independently or in pairs, students explored kitchen safety, equipment and recipe planning before applying their skills through a range of cooking techniques.
Â
In the final stages, students designed, prepared and evaluated their dish, using a design brief and reflecting on the sensory qualities of their creation. It was fantastic to see their creativity come to life in the kitchen!
THURSDAY 26 MARCH 2026
FIT FOR LIFE – CABLE PARK FUN || Our Year 9 & 10 Fit for Life students enjoyed a fantastic day at Melbourne Cable Park yesterday, experiencing a new recreation and leisure activity as part of the program. It was great to see students getting active, challenging themselves and having fun on the water.
THURSDAY 26 MARCH 2026
YEAR 12 JUMPERS || A special moment for our Year 12 students this morning as they received their Year 12 jumpers — a milestone in their final year at the college. A huge thank you to Phoebe Meure for the wonderful design and to India Keech and Eve Oakley for coordinating the process.
THURSDAY 26 MARCH 2026
YEAR 12 JUMPERS || From lining them up to putting them on… a moment our Class of 2026 won’t forget. A great way to mark their final year together.
FRIDAY 27 MARCH 2026
REPRESENTING BSC IN CANBERRA || Year 12 student Vladimir Simonov represented Beaumaris Secondary College at the 31st National Schools Constitutional Convention, held this week at the Museum of Australian Democracy at Old Parliament House in Canberra.
Â
Selected from hundreds of students across Australia, Vlad joined 113 senior students to explore how Australia’s Constitution shapes our democracy. Students heard from national experts, debated key issues and took part in a mock referendum conducted by the Australian Electoral Commission.
Â
The program also included visits to Parliament House, Government House, where students met the Governor-General and the National Press Club of Australia.
Â
The convention concluded with students contributing to a communiqué that will be presented to the President of the Senate and tabled in the Australian Parliament.
Â
A fantastic opportunity and a significant achievement. Well done, Vladimir!
FRIDAY 27 MARCH 2026
VCE BIOLOGY || Our Unit 3 Biology students have been exploring DNA manipulation techniques, applying their learning through a hands-on investigation.
Â
Working in the lab, students transformed bacteria with a gene from Aequorea victoria, a bioluminescent jellyfish. When successful, the bacteria expressed green fluorescent protein (GFP), causing them to glow under UV light.
Â
This practical experience supported students to deepen their understanding of key concepts, including cell structures, enzymes, DNA and RNA, as well as transcription and translation.
Â
It was great to see students engaging with complex scientific processes and bringing their learning to life.
FRIDAY 27 MARCH 2026
STAFF WELLBEING || Last week, staff enjoyed some light-hearted games and refreshments after school — a great opportunity to connect, unwind and share a few laughs. Supporting staff wellbeing helps to create a positive culture that flows through to our learning spaces and wider school community.
SATURDAY 28 MARCH 2026
LUNCHTIME CONCERT || Another Friday lunchtime concert in the amphitheatre, with students sharing their talents. A highlight was our VCE Music Unit 1/2 students, who showcased their ensemble SAC performances. Well done to all performers!
MONDAY 30 MARCH 2026
YEAR 7 OUR WORLD ||Â From fieldwork along the Yarra to final presentations back at school, our Year 7 students have been exploring the health of this vital waterway.
Â
Using data collected during their city excursion, students analysed their findings and created strong final presentations, sharing their conclusions and proposed actions to help protect and improve the river.
MONDAY 30 MARCH 2026
HOUSE ATHLETICS CARNIVAL ||Â House spirit was on full display at our annual Athletics Carnival today! The Year 12 parade, a proud tradition, set the tone for a great day of competition and community.
Â
From track and field events to facepainting, karaoke, popcorn and novelty events, there was something for everyone to enjoy.
Â
Congratulations to Ricketts House, who were announced as the overall winners.
Â
A big thank you to our Year 12 VCE Vocational Major students for running a successful sausage sizzle, and to alumnus Bjorn for photographing the event.
Â
More photos in this week’s newsletter.
TUESDAY 31 MARCH 2026
YEAR 7 SCRIPTED PERFORMANCE PBL || More moments from our Year 7 Create Performance students. Through interpreting scripts and refining their performances, students have built confidence, strengthened collaboration and brought their work to life for an audience.
TUESDAY 31 MARCH 2026Â
NGV TOP ARTS – IAN POTTER CENTRE || Our VCE Art Making and Exhibiting students spent the day at the NGV exploring the annual Top Arts exhibition. The visit offered a first-hand look at high-scoring artworks and folios from the 2025 VCE cohort. By examining the journey from initial concept to final gallery piece, students gained valuable insight into the technical and conceptual standards required for their own work.
WEDNESDAY 1 APRIL 2026
ENSEMBLES CONCERT || Last night’s Ensembles Concert was a wonderful showcase of the talent, dedication and progress of our Instrumental music students. It was fantastic to see students performing with confidence and sharing their music with our college community.
Â
Thank you to our performers, families and dedicated instrumental music staff for making the evening such a special event.
Â